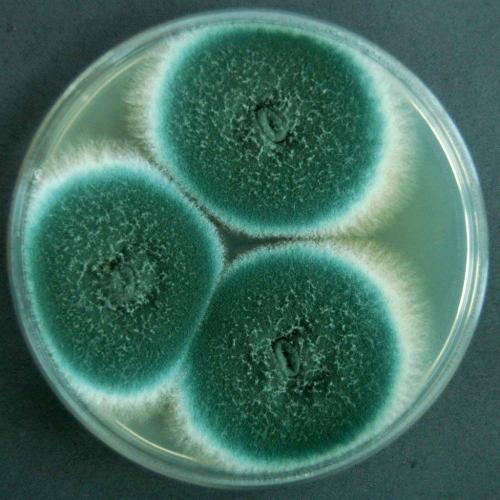

Полезные советы
Избежать появления плесневых грибков также помогут полезные советы:
- Подвальное помещение должно иметь хорошую изоляцию, межпанельные швы нужно при необходимости отремонтировать.
- Отдавать предпочтение распашным моделям металлопластиковых окон, которые обеспечат эффективное проветривание.
- Желательно установить дополнительную вытяжку.
- Если в подвальном помещении есть грунтовые и талые воды, следует устранить проблему, чтобы предотвратить их проникновение в квартиру.
- Постараться завершить ремонт до наступления осеннего периода либо приступать к наклеиванию обоев после включения централизованного отопления.
Уничтожить плесень на обоях самостоятельно нелегко, но возможно при соблюдении всех рекомендаций. По возможности стоит обратиться за помощью к профессионалам. Приступая к ремонту, перед наклеиванием обоев нужно обрабатывать стены антисептическим раствором, чтобы в дальнейшем предотвратить появление плесени.
Способы обнаружения плесени под обоями
Присутствие плесени в квартире несложно заподозрить, если постоянно ощущается неприятный запах сырости подвала или затхлости. В этом случае стоит внимательно осмотреть стены. Если видимых пятен на обоях нет, отодвигают мебель. Возможно, следы грибка скрыты за шкафами и комодами.
Еще одним признаком соседства с плесенью является внезапное ухудшение здоровья без видимых причин. Летающие по квартире споры проникают в организм человека провоцируют обострение хронических болезней и аллергии.
Чаще черные пятна образуются в комнатах, которые выходят углом на улицу. Стены такого помещения промерзают быстрее и отсыревают, давая плесени больше шансов на выживание. Поэтому в первую очередь осматривают угловые помещения, которыми не пользуются часто.
Можно ли избавиться от плесени на обоях самостоятельно?
Если распространилась плесень на обоях, что делать в первую очередь? С хорошего проветривания дома и удаления в нем влажности, а в холодном помещении сделать это невозможно, поэтому добиваемся в жилище теплого сухого воздуха. Подойдут для этого и специальные ионизаторы, и осушители, и обычные бытовые камины и даже фены.
Далее ищем причины проблемы и исходя от размеров зараженных участков просчитываем варианты получится ли убрать плесень с обоев, не сдирая их. Надо понимать, что если черный грибок есть и на обоях, то и под обоями плесень также будет. В таком случае все меры удалить налет будут иметь временный эффект, но это также хорошо, так как не у всех есть силы и возможность сразу же затевать ремонт с удалением зараженной штукатурки и нанесением новой.
Внимание! Плесень может всасываться через кожу, поэтому не прикасаемся к ней голыми руками. Все работы проводим в резиновых перчатках и хорошем респираторе
Избавиться от плесени на обоях не получится за один раз
Важно создать на стенах защитную прослойку, а это серьезный ремонт и использование специальных строительных антисептиков
Если площадь пораженных стен достаточно велика, целесообразно обратиться за помощью в специальную фирму, так как в итоге это окажется дешевле, чем регулярно делать косметические ремонты. Также, не имея опыта в проведении работ по удалению грибка, вы можете только встряхнуть огромнейшее количество спор и плесень распространится и по другим помещениям.
Насколько сильно заражена квартира?
Оцените степень поражения, если 20% поверхности заражено плесневым грибком, то в жилище нельзя находиться людям и косметическим ремонтом не удастся обойтись. Осмотрите внимательно каждую комнату и выясните где больше всего плесени.
Обычно грибок появляется в ванной комнате на плитке, под линолеумом, в нишах, где расположены трубы, за плинтусами, внутри пластиковых панелей. В кухне плесень бывает реже из-за того, что плита нагревает воздух выше 22 С° и не редко в комнате имеется большое окно, из которого льётся солнечный свет, уничтожающий споры грибов.
Частенько плесневеют обои гостиной или спальни, шифоньеры и антресоли, особенно если угловая квартира. Внимательно изучите шкафы и мягкую мебель, возможно, их тоже придётся обработать или заменить. Присмотритесь: не отошли ли обои? Нет ли под ними влажных тёмных пятен?
Убираем плесень с разных типов обоев
Итак, если стена оказалась не заражена, то достаточно убрать плесень только с обоев. Но следует понимать, что с бумажного покрытия вывести плесень жидкими препаратами практически невозможно, особенно если она черная. Если же делать новый ремонт совсем не с руки, то можно попробовать уничтожить зарождающиеся очаги строительным феном, если его нет – просто прогладить обои горячим утюгом. После просушки остатки плесени можно счистить щеткой. Но гарантированно таким методом от этой заразы не избавиться, и если плесень появится снова, обои все же придется переклеить.

С обоев из флизелина или акрила и других видов моющихся покрытий выводить плесень намного проще. Можно воспользоваться специализированными средствами, уничтожающими и грибок, и неприятный запах – фунгицидами. Обработка проводится в соответствии с инструкцией.
Можно использовать и народные рецепты, с помощью которых в домашних условиях выводили плесень еще в старину. Самыми популярными и действенными считаются следующие средства:
- Раствор медного купороса. В 5 литрах теплой воды развести 50 грамм купороса, нанести валиком или щеткой и повторить обработку после высыхания. Недостатком данного метода являются окрашивающие свойства раствора. Так что использовать его можно только на темных поверхностях, на которых не будет заметен синеватый оттенок.
- Раствор натрия гипохлорита. На 5 литров воды берется пол-литра «Белизны или другого хлорсодержащего препарата, хорошо размешивается и наносится на зараженные поверхности в несколько слоев. Для гарантированного уничтожения грибка процедуру рекомендуется повторить.
- Мыльный раствор. Натереть хозяйственное мыло на крупной терке и тщательно растворить в теплой воде. Полученный раствор нанести щеткой на стены. Обработать несколько раз. Средство подходит только для небольших очагов плесневой грибницы.
- Перекись водорода. Так как перекись может обесцветить обои, стоит предварительно попробовать на маленьком кусочке. Несколько обработок эффективно устранят плесень и не дадут заразе снова появиться. При этом перекись совершенно нетоксична, и ее безопасно применять в доме с маленькими детьми.
- Нашатырный спирт. Распылить раствор нашатыря с водой (1:1) на место заражения плесенью, высушить и повторить обработку. Нельзя использовать гидроксид аммония совместно с гипохлоритом натрия, так как при их взаимодействии выделяются ядовитые пары.
- Пищевая сода. Растворить 1 чайную ложку соды в стакане воды и убрать следы плесени с обоев с помощью мягкой губки. Смывать средство не нужно – пропитав обои, оно надолго предохранит стены от нового заражения.
- Столовый уксус. 3% раствор (или разбавленный наполовину водой 9%) распылить на пораженные участки несколько раз и хорошо проветрить помещение. Уксус уничтожит споры и устранит неприятный запах в комнате.
При любом способе обработки наносить препараты стоит не только на видимую область поражения, но и вокруг, чтобы предотвратить распространение плесневой грибницы и повторное заражение.

Каким бы эффективным ни было противогрибковое средство, уничтожена плесень окончательно или придется еще неоднократно проводить обработку, покажет только время. Для устранения больших очагов заражения лучше вызывать специалистов, которые не только качественно уничтожат споры, но и дадут гарантию на свою работу.
Причины
Грибок начинает активно размножаться только при попадании в хорошую для нее среду. Споры могут несколько лет находиться в неактивном состоянии, а когда появятся хорошие условия для них, начинают размножаться.
Грибок появляется в местах где достаточно влажно и сыро. Чтобы его устранить необходимо выяснить причину появления.
От нее невозможно избавиться, не зная почему она начала появляться.
Причины:
- Конденсат в результате недостаточного проветривания или вентиляции является одной из основных причин роста споров. Ванные комнаты являются хорошим примером. Именно в них чаще всего образуется плесень на обоях, а затем переходит в другие комнаты квартиры.
- Близко поставленная мебель к стене. Создается недостаточная циркуляция воздуха, что приводит к повышенной влажности.
- Неисправность труб в санитарных узлах и на кухне.
- Старые батареи, которые начали протекать в местах соединения с другими частями отопительных приборов.
- Некачественно установленные стеклопакеты. В них может собираться конденсат.
- Протекающая крыша также может привести к ее образованию. Грибок является медленным процессом и не появляется в одночасье.
- Повышенная влажность в квартире из-за большого количества растений, или при наличии увлажнителей воздуха.
- Резкие скачки температуры в комнатах.
- Утепление стен без расчета паропроницаемости используемых материалов.
Недостаточно просто использовать какой-либо метод, чтобы удалить плесень с обоев. Нужно для начала выяснить причину ее образования.
В противном случае через некоторое время грибок снова проявится черными пятнами, и придется повторять его выведение.
Народные средства
Избавиться от плесени на обоях и уничтожить плесень под обоями, когда бумажное покрытие уже сорвано, можно и домашними средствами. При работе также необходимы средства индивидуальной защиты.
Медный купорос
Благодаря дезинфицирующим свойствам, медный купорос эффективно справляется с грибком.
- Порошок медного купороса растворяют в теплой воде, рассчитывая, что на каждый литр требуется столовая ложка средства.
- При помощи валика раствором покрывают все стены.
Повторяют обработку после полного высыхания.
Отбеливатель
Помогают устранить плесень бытовые средства, содержащие хлор.
- Вливают 500 мл средства в пять литров воды.
- Тщательно перемешивают раствор.
- Кистью распределяют по плоскостям стен.
- Повторяют до пяти раз, дожидаясь полного высыхания предыдущего слоя.
Помещение во время обработки проветривают.
Хозяйственное мыло
Заметив первые признаки плесени на обоях, применяют 72-процентное хозяйственное мыло без щелочи и ароматизаторов.
- Брусок измельчают на крупной терке.
- Растворяют в трех литрах теплой воды.
- Размешивают до получения однородной консистенции.
- Мыльным раствором мягкой губкой или щеткой смывают плесневый слой.
При необходимости проводят несколько очищающих манипуляций, дожидаясь каждый раз полного высыхания нанесенного слоя.
Уксус
Способствует избавлению от плесени 9-процентный столовый уксус.
- Средство заливают в пульверизатор и орошают зараженную поверхность.
- Через час протирают обработанные плоскости губкой, смоченной чистой водой.
Этот способ особенно эффективен при сильном затхлом запахе, распространяющемся по квартире от стен с плесенью. Уксус убирает неприятный аромат при условии тщательного проветривания помещения после дезинфекции.
Сода и уксус
Эти вещества менее токсичны, чем хлорсодержащие препараты.
- На участок с плесенью обильно распыляют уксус.
- Берут мягкую губку, слегка увлажняет ее и набирают соду.
- Протирают поверхность.
- Затем снова распыляют уксус.
- В результате реакции нейтрализации, в которую вступают компоненты, развитие грибка прекращается.
Повторяют процедуру через день в течение месяца.
Перекись и сода
Усиливает антисептические свойства соды перекись водорода.
- Добавляют в соду небольшими порциями теплую воду.
- Размешивают до получения консистенции кашицы.
- Распределяют по обоям.
- Затем из пульверизатора орошают пораженный участок 3-процентной перекисью водорода.
В результате реакции поверхность очищается.
Нашатырный спирт
Нашатырь помогает убрать следы грибка с твердых поверхностей стены.
- Препарат смешивают с водой в равных долях.
- При помощи распылителя наносят на пораженные участки.
После высыхания повторяют процесс.
Решая, как вывести плесень с моющихся плотных обоев, если обнаружены незначительные ее следы, используют перекись водорода, обладающую противогрибковыми свойствами. Смоченной в средстве губкой несколько раз протирают загрязнения. Из-за отбеливающего эффекта нельзя использовать перекись на цветных и темных обоях.
Хорошо справляется с отдельными отметинами плесени сода, превращенная в кашицу при добавлении воды. Ею несколько раз обрабатывают зараженные плоскости и не смывают.
Можно уничтожить грибок при помощи ультрафиолетовой лампы. Включив ее, направляют световой поток на заражённый участок, выходят из комнаты. Периодически включают лампу в помещениях для предупреждения появления плесени.
Обширное поражение плесенью под обоями
Если плесень покрыла все обои и стала черной, спасать придется в том числе и стены, которые также будут ею поражены. В этом случае придется обои все-таки содрать. Штукатурку надо тщательно осмотреть по всему периметру. Потому что если появилась плесень под обоями и как избавиться от нее непонятно, следует начинать со штукатурки.
Если она в некоторых местах влажная и более темная, значит грибок успел добраться и до нее. Ее надо будет обработать специальной грунтовкой, предназначенной для борьбы с грибком. После этого на стены снова наносится еще один слой штукатурки. И перед поклейкой обоев она должна хорошо просохнуть.
Предотвращение
Все знакомы с поговоркой: «Профилактика — лучшее лекарство».
Чтобы эта красавица не облюбовала вашу уютный дом, соблюдайте несколько простых правил:
- Используйте гигрометр для определения влажности.
- Не ставьте мебель вплотную к стенам, оставьте немного места между ними, чтобы воздух мог свободно циркулировать.
- Если дом затопило, убедитесь, что обои высохли. Убедитесь, что споры не появились.
- После принятия душа и готовки пищи хорошо проветривайте помещение.
- Не допускайте охлаждения комнат.
- Не закрывайте отопительные приборами панелями или шторами. Такое действие не позволяет воздуху нормально циркулировать.
- Утепляйте квартиры. Это предотвратит появление плесени.
- Убирая квартиры, всегда вытирайте все насухо. Не протирайте обои мокрыми тряпками, если ребенок разукрасил их. Лучше воспользуйтесь меламиновой губкой.
Предотвратить плесень можно. Только усилия придется прикладывать ежедневно.
Грибок на стенах — это настоящая катастрофа. Он быстро размножается и атакует все участки дома, с обоев он перебирается стены, а далее поражает все комнаты.
Черные разводы на обоях — плохой знак. Их следует немедленно удалять, ведь спустя несколько дней их можно обнаружить в другой комнате.
Как избавиться от плесени на обоях
Итак, мы определились, что выводить грибок и плесень перед поклейкой обоев необходимо в обязательном порядке. Однако первым делом стоит установить причину появления вредителей.
Возможно у вас слишком плотные окна ПВХ, или где-то подтекают трубы. Внимательно осмотрите вашу квартиру и устраните саму причину, чтобы после ремонта грибок и плесень не возникли вновь. Вообще — это первое, что нужно сделать — устранить первопричину образования паразитов. Часто такая причина кроется в сырости, которая может появляться по ряду причин: от плохих окон, до протечки труб.
Первым делом, необходимо при помощи шпателя в местах, где плесень буквально въелась в стены, удалить слой штукатурки. После проведения этих работ, стены необходимо зачистить наждачной бумагой.
Далее переходим к обработке поверхности специальным раствором против грибка и плесени. Купить такой раствор можно в любом строительном магазине.
В процессе нанесения раствора на стены, в обязательном порядке наденьте защитный костюм, чтобы избежать попадание раствора на участки кожи.
Желательно при обработке стен, обработать не только места, где есть грибок и плесень, а захватить слегка больше. Не скупитесь на обработку, лучше дополнительно пройтись еще раз, чтобы быть уверенными на верняка, что вы сделали все правильно и качественно.
Профессиональная химия
Химическая промышленность сегодня выпускает большое количество средств для борьбы с плесенью в домашних условиях. Ассортимент широкий, цены – на любой кошелек.
Чтобы избавиться от плесени указанным способом, важно соблюдать рекомендации на этикетке товара и технику безопасности. Если в доме есть домашние животные, то об их здоровье следует позаботиться: переселить из квартиры на время работы с профессиональной химией
В списках популярных средств данной категории выделяются следующие: Odorgone Professional for home, Dale, Cillit Bang, «ФонгифлюидАльпа», Avena Color, KOLORIT Start BIOSTOP, Mellerud, Well Done, «Мавикс-био», Sanitol, XADO, Caparol Capatox.
Народные методы против плесени
Народные методы борьбы не дадут стопроцентную гарантию исчезновения пятен на обоях. Необходимо не только провести несколько обработок, но и подкорректировать домашний микроклимат. Именно он часто является главной причиной появления и дальнейшей жизнедеятельности черных пятен.
Чтобы уничтожить плесень, подойдут следующие средства:
Хлор
Торговые названия могут быть разными (Domestos, «Сантри», «Белизна»), важно, чтобы в составе было это вещество. При выборе такого способа борьбы, требуется обезопасить руки, надев хозяйственные перчатки
Развести выбранное средство нужно с водой в пропорции 1:10. Полученным раствором смочить губку и оттирать пятна. По окончании обработки промыть поверхность с хозяйственным мылом.
Медный купорос. Этот способ подойдет тем, у кого обои синих оттенков, поскольку купорос красит поверхность. Порошок разводят водой в пропорции 50 гр на 5 л. С помощью валика наносят раствор на стены. При необходимости повторяют процедуру.
Уксус. Налить его в пульверизатор и распылить на плесень. Спустя час промыть стены водой.
Сода. Развести водой (2 ст. л. на 1 л) и полученным раствором промыть обои. В случае с содой смывать ее со стен не надо, поскольку она станет барьером от появления новых пятен плесени.
Нашатырный спирт. Смешать с водой, раствор налить в пульверизатор и распылить на зараженную поверхность. После высыхания процедуру повторить, а потом проветрить комнату.
Перекись водорода и сода. Кашицу из соды и воды нанести на стены, а поверх распылить перекисью водорода. После окончания шипения остатки средства убрать влажной губкой. У этого способа есть особенности: в итоге химической реакции сода и перекись слегка отбелят поверхность обоев.
Как вывести своими руками, если ничего не помогает?
Если на обоях стали видны черные точки плесени, это значит, что очаг проблемы находится на стене, а значит обычным чистящим средствам с грибком не справиться. В этом случае поможет только глобальный ремонт, который будет проходить в несколько этапов:
-
В первую очередь нужно сорвать обои с пораженного участка. Чтобы после ремонта плесень не появилась снова, рекомендуется работать с зоной, превышающей место загрязнения на два метра в радиусе, так есть шанс избавиться от очагов, которые не успели проявиться на обоях.
- Следующим этапом нужно вычислить все испорченные участки. В местах роста плесени штукатурка будет мягкая и податливая. Ее нужно счистить металлической щеткой так, чтобы оставшиеся зоны все были крепкие и нетронутые грибком.
- На третьем этапе надо обработать стены химическим составом, который предотвратит возвращение проблемы. Здесь в работу вступают такие средства, как Sanitol Spectra. После его нанесения нужно дать химии немного времени впитаться и высохнуть.
- В завершение ремонта неровности стены устраняются с помощью шпаклевки, которая после высыхания еще раз обрабатывается химическими средствами. Только по завершению этого этапа можно вновь клеить обои.
Если плесень одолела большую часть стены или комнаты, не надо пытаться бороться с ней самостоятельно. Лучше вызвать бригаду Санитарно-эпидемиологической станции, потому что проблема может быть гораздо серьезнее, чем излишняя влажность.
Таким образом, можно сэкономить время и деньги, а главное не придется играть со здоровьем жителей квартиры.
Узнайте подробнее о том, как удалить черную плесень с потолка и стен жилого помещения.

Как избавиться от плесени
Устранения причин
Итак, с причинами возникновения этой проблемы мы разобрались. Теперь рассмотрим,что делать если под обоями плесень после ремонта. Вариантов, на самом деле, не много.
Прежде чем убрать плесень с обоев, необходимо устранить причины ее возникновения, т.е. нужно привести в норму уровень влажности в помещении и обеспечить хорошую вентиляцию. При необходимости, следует выполнить гидроизоляцию пола.
Все вышеописанные меры позволят остановить размножение грибка. Однако, хозяев жилья всегда интересует, чем удалить плесень с обоев?К сожалению, с обоями придется расстаться.
Дело в том, что ни одно средство от плесени на обоях не позволит полностью избавиться от пятен на стенах. И даже, если вы их сотрете и сделаете практически незаметными, то со временем они снова появятся. Поэтому покрытие необходимо полностью сорвать, в том числе и чистые участки, на которых нет плесени.
Регулярное проветривание позволит снизить влажность в помещении
Данная процедура нужна для того, чтобы избавиться от всех спор, даже тех, которые невидимы для нашего глаза. Это даст гарантию, что после выполнения отделки, вам не придется в скором времени опять срывать покрытие.
Удаление обоев
Подготовка
Итак, приступая к борьбе с плесенью, вначале необходимо подготовить стены к дальнейшей обработке.
Инструкция выглядит следующим образом:
- Всю мебель необходимо вынести из помещения и протереть смоченной тряпкой в перекиси водорода.
- Затем надо содрать со стен обои, уложить их в пластиковые мешки и отправить в мусор.
- Далее стены следует хорошо зачистить своими руками при помощи жесткой металлической щетки или грубой наждачной бумаги.
- После этого нужно удалить со стен непрочно держащуюся шпаклевку и штукатурку.
- В завершение подготовительных работ, стены надо очистить от пыли. Можно даже их помыть и после этого высушить.
На фото – обработка стен бактерицидным средством
Обработка стен
Дальнейшая работа выполняется в следующем порядке:
- Если имеется возможность, то помещение следует обработать ультрафиолетом.
- Далее стены обрабатываются специальным противогрибковым составом. Также отличным средством является медный купорос, который обладает фунгицидным действием. Состав наносится при помощи валика для покраски и распределяется равномерным слоем по всей поверхности.
- После высыхания, стены нужно еще раз очистить щеткой, чтобы удалить продукты распада микроорганизмов и органики.
- Затем поверхность тщательно вымывается теплой водой.
- После этого, на стены наносится грунтовый состав, обладающий бактерицидным свойством. Для достижения максимального эффекта, обработка стен от плесени перед поклейкой обоев выполняется несколько раз. Каждый последующий слой наносится после высыхания предыдущего.
На этом обработка помещения завершена. При соблюдении всех вышеизложенных этапов, вы забудете о плесени на долгие годы.
Средства против плесени
Теперь осталась только отделка стен – надо прошпаклевать их и наклеить новые обои. При этом не забывайте, что после шпатлевания стены нужно обработать грунтовкой еще раз.
Что делать, чтобы плесень больше не беспокоила
Не зная, как избавиться от плесени на обоях и стенах, перед владельцами квартиры или дома возникает еще один актуальный вопрос. Хочется понять, какие меры позволят не допустить такой проблемы в будущем. И в это случае можно руководствоваться следующими рекомендациями:
надо проверить исправность работы вентиляционный системы и при необходимости установить вытяжку;
не стоит забывать про регулярное проветривание помещения;
важно открывать шторы на окнах, чтобы солнечные лучи попадали в комнату;
в ванной комнате полезно оставлять дверь открытой, особенно после очередного пользования ею;
во время готовки крышки посуды лучше закрывать, чтобы комната не наполнялась паром, создавая повышенную влажность;
металлические трубы следует заменить на пластиковые, чтобы на них не образовывался конденсат;
мебель не стоит ставить вплотную к стене, так как из-за этого нарушается циркуляция воздуха.
Придерживаясь таких несложных рекомендаций удастся не только забыть о плесени, но и предупредить ее возможное появление.
Меры профилактики возникновения плесени в жилище
Проводите регулярное проветривание квартиры и следите, чтобы работа вентиляционной системы была организована правильно. Так можно «выгнать» из помещения излишнюю влагу.
Своевременно избавляйтесь от пораженных гнилью овощей, чтобы не допустить распространения спор грибка по квартире.
Современные окна, сделанные из пластика и герметично закрывающиеся, могут стать причиной возникновения плесени. В качестве меры, позволяющей не допустить ее распространения, имеет смысл установить на стеклопакетах специальные клапаны для вентиляции.
Не следует слишком плотно придвигать к стенам мебель, особенно мягкую
Чаще всего в таких «закутках» и образуется грибок.
Чтобы предотвратить появление плесени на стенах комнат, можно окрасить оконные проёмы краской на гидрофобной основе.
Важно следить за качественной заделкой щелей в стенах дома, чтобы не допустить протекания воды.
Предотвратить появление плесени намного легче, чем бороться с ней или страдать от её пагубного воздействия на организм
Поэтому настолько важно соблюдать все меры профилактики и своевременно начинать борьбу с этой проблемой

Профилактика
Однажды столкнувшись с заплесневелостью, можно убедиться, что избавление от нее может отнять много времени, поэтому лучше не допускать ее повторного возникновения. Подведём итоги, как избавиться от плесени под обоями:
- Регулярно проветривать помещение.
- При готовке включать вытяжку (специальная система принудительного проветривания) или открывать окно на кухне.
- Откосы следует покрыть водоотталкивающей краской, что бы конденсат не застаивался на окнах.
- Не ставить мебель впритык к стенам, стоит оставлять пару сантиметров для циркуляции воздуха.
- Проверьте систему вентиляции, устраните засор канала при необходимости.
- Почаще держите открытой дверь в ванную комнату и держите открытой дверцу душевой кабины.
- Если у вас угловая квартира, задумайтесь об утеплении стен.
- Следите за состоянием стиральной машинки, на резиновом уплотнителе часто возникает черный налет.
Эти простые правила позволят избежать появления черной заплесневелости. Если же проблема уже возникла, то вы знаете, что с ней можно справится самостоятельно. Если такой возможности нет, то всегда можно обратиться к специалистам.
Применение профессиональных химикатов
После очищения плесени на обоях в квартире вместо народных средств можно использовать специальные химические препараты. Такие средства продаются в строительных и хозяйственных магазинах или на рынке.
Эффективно устраняет грибок фунгицидный раствор. Его смешивают с водой по имеющейся на упаковке инструкции и обрабатывают стены. Для предотвращения повторного возникновения плесени средство наносят на все поверхности, а не только там, где были обнаружены пятна. Похожим действием обладают препараты Ксиолат и Фитолайн.
Когда обработанная поверхность просохнет, дополнительно стены покрывают антисептиком. Это улучшит результат и предупредит образование плесневелых пятен в будущем.
Во время проведения работ, чтобы удалить плесень с обоев, важно соблюдать осторожность. Чтобы споры не попали на кожу и слизистые дыхательных органов, надевают респиратор, резиновые перчатки и полностью закрывают все части тела одеждой
При работе с уксусом и средствами с содержанием хлора нельзя допускать контакта с кожей и слизистыми, чтобы избежать сильного ожога
Также важно помнить, что хлор и перекись водорода обладают отбеливающими свойствами. Поэтому их можно использовать только на светлых поверхностях
После окончания работы защитную одежду снимают и сразу же стирают. Очки и перчатки протирают раствором пищевой соды или любым противогрибковым средством.
Плесень и здоровье

Нахождение человека в помещении, пораженном плесневым грибком, весьма опасно. Даже без тактильного контакта микроспоры проникают в организм через легкие и кожу и отравляют его. Длительный контакт с плесенью может привести к следующим проблемам со здоровьем:
- общее снижение иммунитета;
- ухудшение общего самочувствия и повышенная утомляемость;
- головные боли;
- аллергические реакции;
- хронические риниты и синуситы;
- учащение болезней дыхательных путей (вплоть до астмы);
- носовые и внутренние кровотечения;
- раковые заболевания.
В зону особого риска попадают маленькие дети и люди с ослабленным болезнью или старостью иммунитетом.
Аспергилл дымящийся вызывает аллергию, аспергиллез и воспаление легких.
Аспергилл дымящийся вызывает аллергию, аспергиллез и воспаление легких.

 Кладоспорий травяной приводит к развитию аллергического заболевания — ринита, бронхиальной астмы, и пневмонии.
Кладоспорий травяной приводит к развитию аллергического заболевания — ринита, бронхиальной астмы, и пневмонии.

 В доме, где появился Стакиботрис атра страдают от мигрени, развивается астма, кашель, слезятся глаза.
В доме, где появился Стакиботрис атра страдают от мигрени, развивается астма, кашель, слезятся глаза.
 Аспергилл дымящий вызывает осложнения заболеваний дыхательных путей, астму, респираторные заболевания.
Аспергилл дымящий вызывает осложнения заболеваний дыхательных путей, астму, респираторные заболевания.

 Пеницилл – возбудитель таких болезней как астма и аллергия.
Пеницилл – возбудитель таких болезней как астма и аллергия.
Методы борьбы с грибком
Прежде чем убрать грибок с обоев, необходимо позаботиться о мерах предосторожности при работе с плесенью. Нужно приобрести резиновые перчатки, респиратор и надеть старую одежду, которую потом будет не жалко выкинуть
После этого можно приступать к работе:
- Снятие со стен обоев.Пораженные обои необходимо удалить со стен, так как убрать с них плесень невозможно. Некоторые пытаются вывести пятна при помощи мыла и губки, но нужно понимать, что грибок проникает глубоко в поверхность. Просто промыв обои, от него не удастся избавиться.
- Обработка стен.Под пораженными участками обоев следует шпателем или металлической лопаткой убрать слой штукатурки. Там тоже сохраняются клетки грибка. Из-за повышенной влажности сделать это будет достаточно легко. Зачищать стены необходимо как можно тщательнее, чтобы максимально удалить плесень.
- Обработка поверхности защитным раствором.На полках строительных магазинов можно встретить большое разнообразие различных фунгицидных растворов. Наиболее популярными и действенными считают «Фитолан» и «Ксиолат». По составу оба средства идентичны, поэтому выбрать можно одно из них. Разводить купленный раствор нужно четко по инструкции и после этого наносить на поврежденные участки.Для профилактики рекомендуется обработать средством всю площадь стен, так как грибок способен прятаться глубоко внутри нее и никак себя не проявлять. Наносят раствор на 6 часов, а по истечении этого времени можно повторить процедуру.
- Применение антисептика.После полного высыхания фунгицидного раствора поверхность стен необходимо обработать антисептическим препаратом. Это поможет избежать повторного появления грибка. Приобрести полезную грунтовку можно в любом строительном магазине и чаще всего она полностью готова к применению.Широкой кистью или при помощи пульверизатора на сухую поверхность наносят средство и оставляют до полного высыхания. Как правило, это занимает не более шести часов. После этого следует убрать остатки плесени и нанести раствор еще раз.
- Шпаклевка и оклейка стен обоями.После обработки стен фунгицидами и антисептиком и просушки можно зашпаклевать поверхность при помощи шпателя. А когда она полностью высохнет, можно приступать к поклейке обоев.
Многие даже не догадываются о масштабах трагедии, предпочитая замыть черные пятна или поменять только поврежденный участок обоев. На самом деле проблема кроется намного глубже. Только выполнение перечисленных рекомендаций поможет навсегда избавиться от плесени на обоях в квартире при условии, что также решена проблема с вентиляцией.
Самостоятельное избавление от плесени на обоях
Некоторые люди с удовольствием перепоручают войну с плесенью профессионалам, но далеко не каждый может позволить себе подобные затраты (особенно, если все накопления уже потрачены на косметический ремонт).
Для начала можно попытаться удалить элементарными вещами — проветривать комнату, держать определенную температуру в квартире. Конечно, необходимо избавиться от источника неприятностей — заделать швы, убрать течи, вернуть нормальную циркуляцию воздуха.
Удалить плесень, не сдирая обои, тоже возможно, но только если очаги поражения очень маленькие. Избавляйтесь в домашних условиях от грибка строго соблюдая порядок действий при обработке стен, а еще пользуйтесь проверенными средствами.
Первый этап — подготовка к зачистке
Из комнаты выносят всю мебель, которую хорошо протирают ветошью, смоченной в перекиси водорода. Если участок плесени достиг больших размеров, то обои снимают, складывают в мешки и уничтожают — плесень на обоях имеет свойство оставаться в воздухе. Лучше всего — сжечь.
Жесткой металлической щеткой или наждачной бумагой зачищают стены, чтобы удалить плесень
Здесь важно работать в респираторе, чтобы не заболеть. Штукатурку тоже придется счистить до самого бетонного основания, ведь она также поражена плесенью
В конце стены очищают от пыли — будет идеально, если поверхность хорошо помыть и высушить.
Второй этап — обработка
Этот этап позволяет полностью избавиться от плесени в квартире. Стены желательно обработать ультрафиолетовыми лучами, если есть такая возможность. При помощи валика на всю поверхность толстым слоем наносится противогрибковое средство.
Затем стену необходимо помыть, заглядывая во все уголки, даже самые труднодоступные. И в завершении на поверхность наносят грунтовку с противогрибковыми компонентами. Лучше сделать несколько слоев, нанося новый, после полного высыхания предыдущего.
Помните о некоторых мерах предосторожности. Обязательно пользуйтесь респиратором не только при очистке стены — работая с резко пахнущими составами можно заработать ожог слизистой
Если используется хлор, растворитель или отбеливатель, помните, что они могут осветлить мебель и обои. После окончания работ одежду необходимо постирать (или выкинуть, если не жалко), а очки протереть раствором натрия двууглекислого.
Чем вредна плесень для здоровья человека
Животным и людям, живущим в доме или квартире, наносит ущерб не сама плесень на обоях, а ее споры, витающие в воздухе. Если долго подвергаться ее воздействию, то это приведет к серьезным заболеваниям. Речь идет, в основном, о различных инфекциях и заболеваниях дыхательных путей: удушьях, астме, аллергии, конъюнктивите. Страдает и кожный покров от экземы и дерматита.
Грибок пагубно влияет и на животных, ведь они теряют возможность нормально дышать. При этом уже существующие заболевания могут перейти в разряд хронических.
Больше всего страдают люди с ослабленным иммунитетом — пожилые и дети. К сожалению, плесень еще недостаточно изучена, поэтому часто врачи ставят не тот диагноз. Грибки поражают даже волосы и ногти, а в особо запущенных случаях даже приводят к летальному исходу.
https://youtube.com/watch?v=-ekTy_wfefs
Если вы затеяли ремонт, то проведите предупредительные мероприятия, и начинайте войну с плесенью сразу же, как только заметили первое пятно. Так вы убережете себя и своих близких от опасности, а еще сэкономите деньги на ремонте.





















